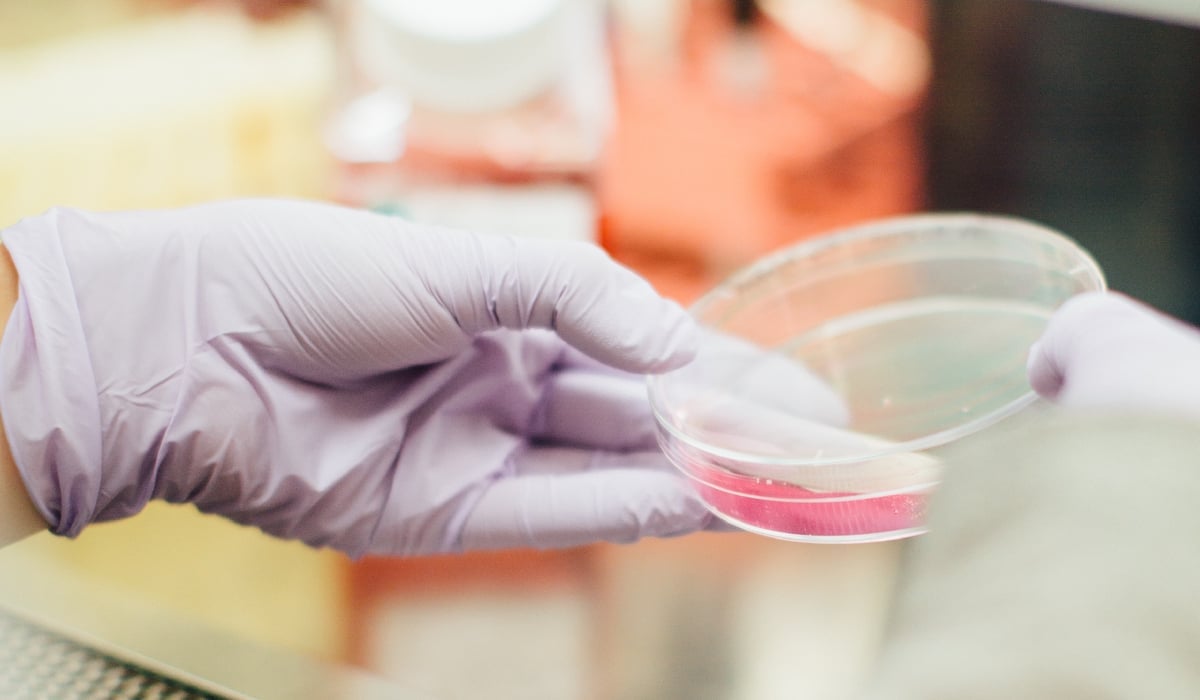

Kvalitet och patientsäkerhet
Södertälje sjukhus ska erbjuda patienter en högkvalitativ och säker vård med hög tillgänglighet samtidigt som kompetenta medarbetare och optimala mellanmänskliga möten bidrar till tillit och tilltro samt hög patient- och kundnöjdhet.
Innehåll

Kvalitets- och patientsäkerhetsberättelse
Arbetet med patientsäkerhet och kvalitet hör ihop. Som vårdgivare ska vi arbeta systematiskt med patientsäkerhet.
Nationella kvalitetsregister
I nationella kvalitetsregister samlas data från hela landet om specifika sjukdomar eller behandlingar för att utvärdera och förbättra vården.
Biobankslagen
Dina blod- och vävnadsprover som tas på sjukhuset kan komma att användas för vård, behandling och/eller forskning.
Lex Maria
Vid allvarlig vårdskada eller risk för sådan är vi som vårdgivaren skyldig att utreda händelsen för att förhindra upprepning.